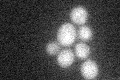
YGR268C
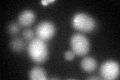
YGR268C
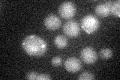
YGR268C

View description
Cytoplasmic protein containing a zinc finger domain with sequence similarity to that of Type I J-proteins; computational analysis of large-scale protein-protein interaction data suggests a possible role in actin patch assembly
Localization:
Intensity:
Fold change:
Significance:
-
C’ GFP library in SD
cytosol24.34 -
N' NOP1pr-GFP in SD

punctate,nucleus70.3226 -
N' TEF2pr-mCherry in SD

below threshold0 -
N' NATIVEpr-GFP in SD

punctate24.9259 -
N' TEF2pr-VC and Cyto-VN in SD

#N/A0 -
C’ GFP library in SD+DTT
cytosol33.391.37Yes -
C’ GFP library in SD+H2O2

cytosol23.260.95No -
C’ GFP library in Starvation Media
cytosol24.220.99No -
C’ GFP library on the background of Pup2-DaMP

cytosol -
C’ GFP library on the background of CCT mutant

cytosol21.6030.887031No
